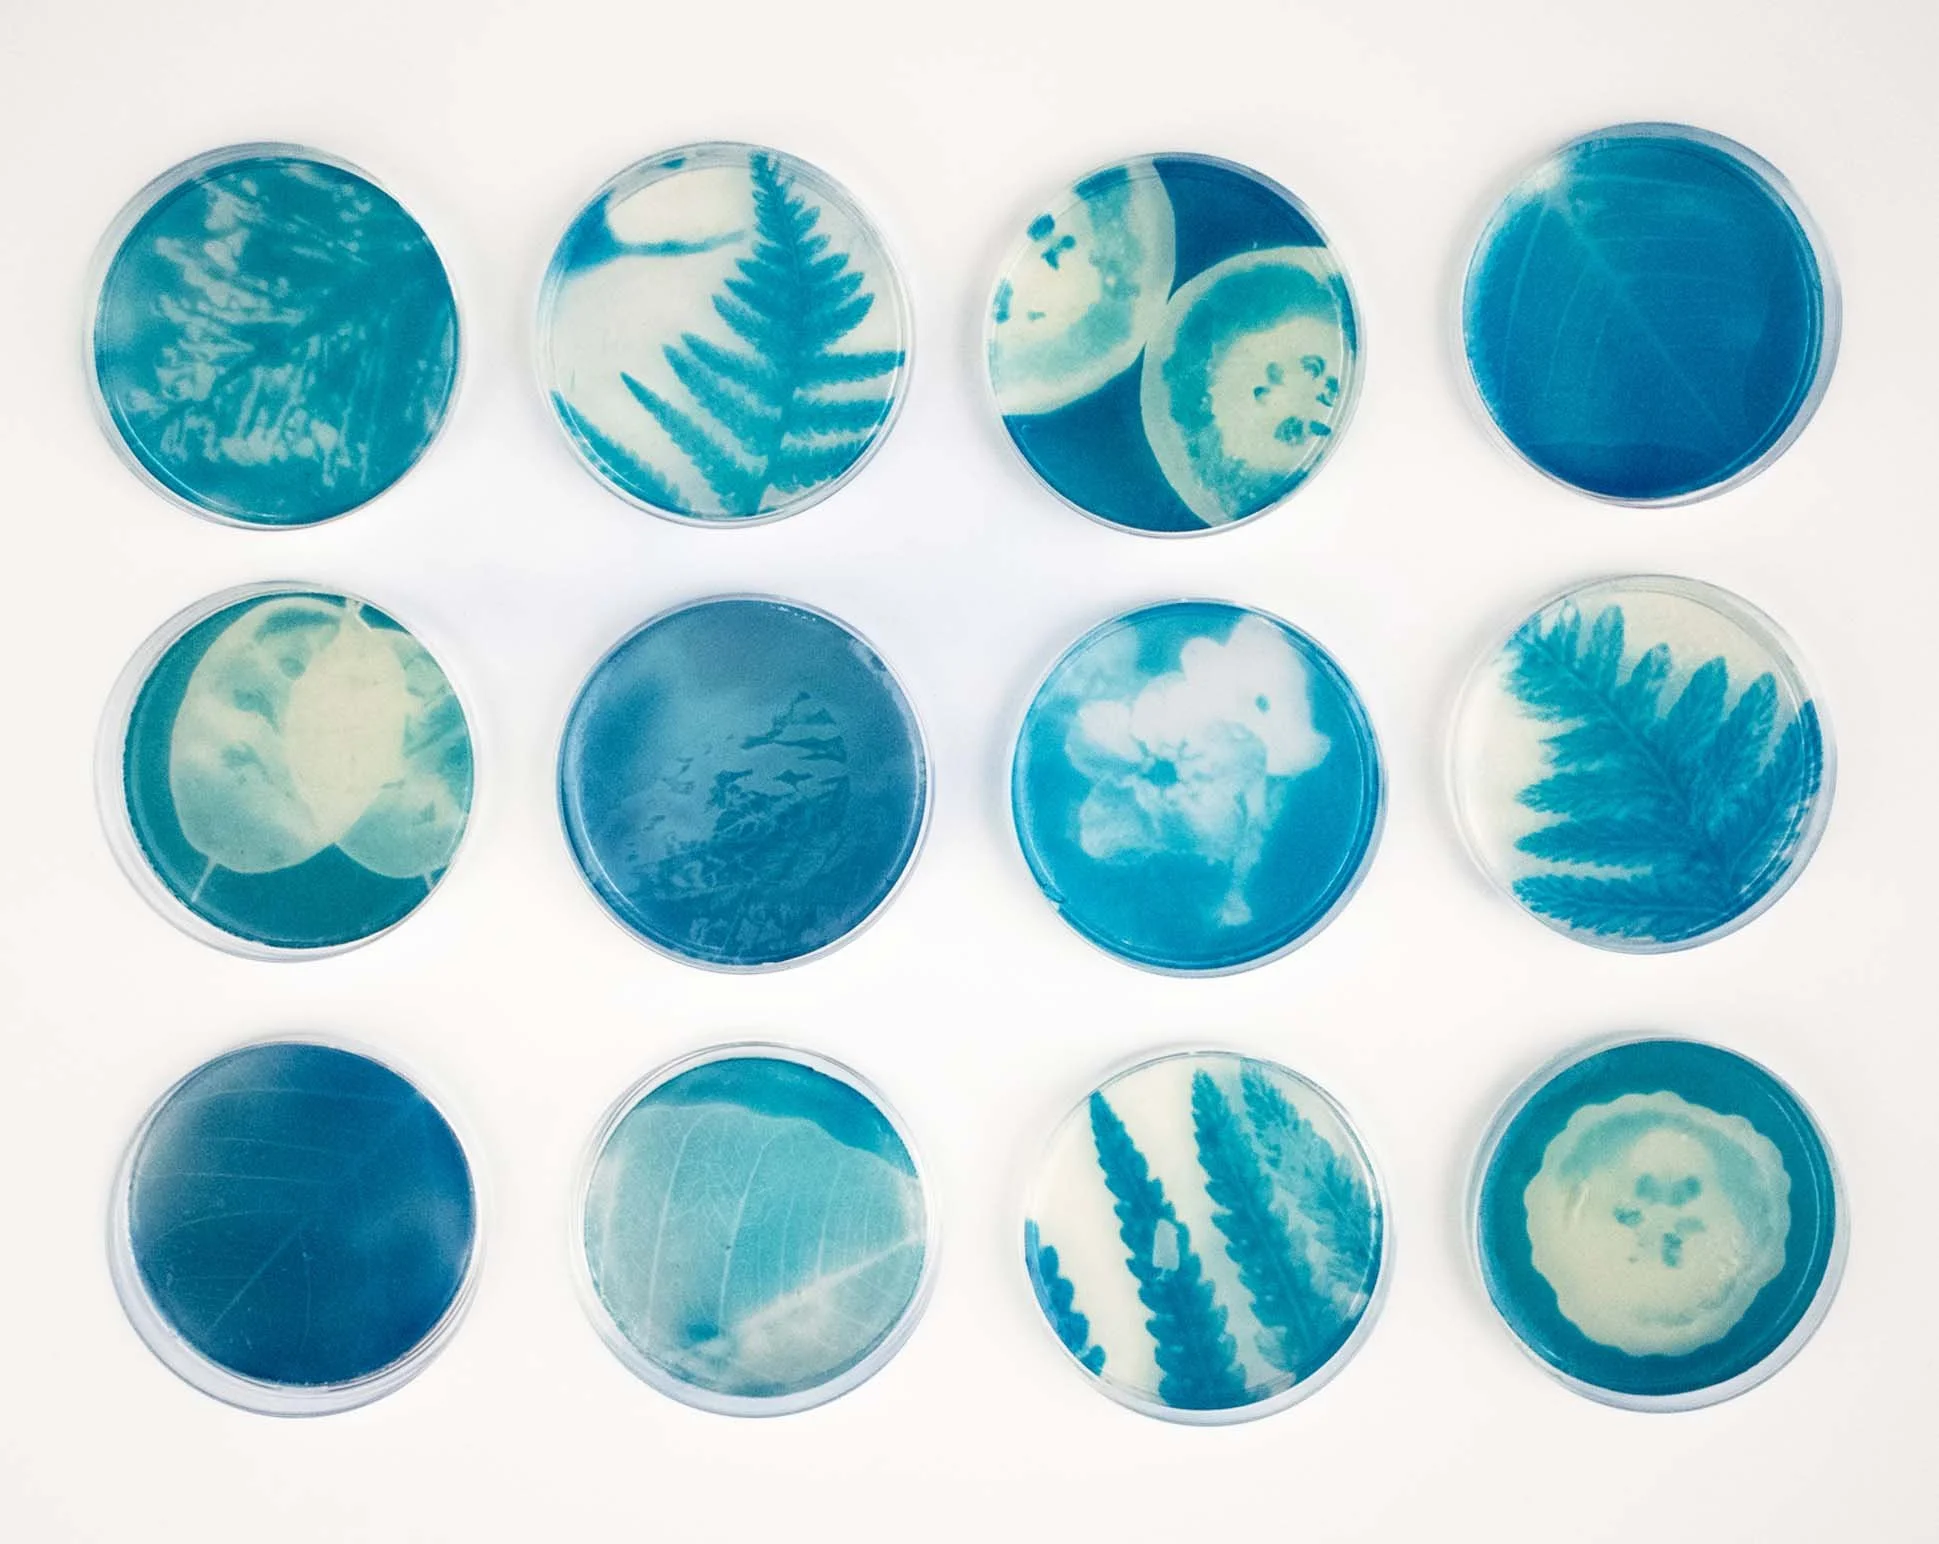
the12 copy.jpg

BA23C(2025) is a body of work that grew out of time spent researching in a medical lab, where it became clear just how important photography and art are within scientific practice. The series brings together cyanotype images of cells, food, plants, and seeds, created on to agar agar inside petri dishes. By combining art and science, the work explores the fine line between the two and how closely they overlap. Each piece reflects on observation, experimentation, and curiosity, while also highlighting the importance of the arts within education. The project was later put together in to a book.
Previous
Previous